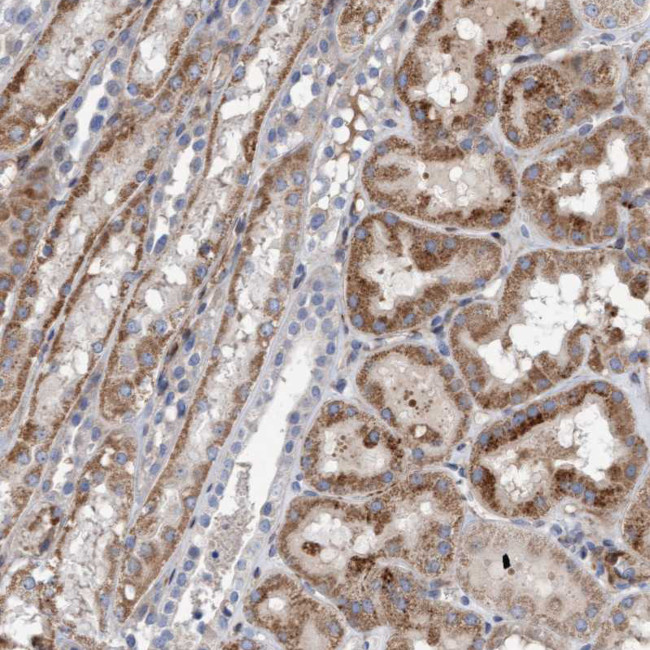
POLG2 Antibody in Immunohistochemistry (IHC)

Search
Invitrogen
POLG2 Polyclonal Antibody
{{$productOrderCtrl.translations['antibody.pdp.commerceCard.promotion.promotions']}}
{{$productOrderCtrl.translations['antibody.pdp.commerceCard.promotion.viewpromo']}}
{{$productOrderCtrl.translations['antibody.pdp.commerceCard.promotion.promocode']}}: {{promo.promoCode}} {{promo.promoTitle}} {{promo.promoDescription}}. {{$productOrderCtrl.translations['antibody.pdp.commerceCard.promotion.learnmore']}}
产品信息
PA5-54721
种属反应
宿主/亚型
分类
类型
抗原
偶联物
形式
浓度
规格
纯化类型
保存液
内含物
保存条件
运输条件
RRID
产品详细信息
Immunogen sequence: LDRGMLAYLY DSFQLTENSF TRKKNLHRKV LKLHPCLAPI KVALDVGRGP TLELRQVCQG LFNELLENGI SVWPGYLETM QSSLEQLYSK YDEMSILFTV LVTETTLENG LIHLRSRDTT MKE
Highest antigen sequence identity to the following orthologs: Mouse - 86%, Rat - 89%.
靶标信息
This gene encodes the processivity subunit of the mitochondrial DNA polymerase gamma. The encoded protein forms a heterotrimer containing one catalytic subunit and two processivity subunits. This protein enhances DNA binding and promotes processive DNA synthesis. Mutations in this gene result in autosomal dominant progressive external ophthalmoplegia with mitochondrial DNA deletions.
仅用于科研。不用于诊断过程。未经明确授权不得转售。
篇参考文献 (0)
生物信息学
蛋白别名: DNA polymerase gamma accessory 55 kDa subunit; DNA polymerase subunit gamma-2; DNA polymerase subunit gamma-2, mitochondrial; Hp55; Mitochondrial DNA polymerase accessory subunit; mitochondrial DNA polymerase subunit gamma-2; mitochondrial DNA polymerase, accessory subunit; MtPolB; p55; PolG-beta; polymerase (DNA directed), gamma 2, accessory subunit; polymerase (DNA) gamma 2, accessory subunit; processivity factor for mitochondrial DNA polymerase catalytic subunit
基因别名: HP55; MTDPS16; MTDPS16A; MTDPS16B; MTPOLB; PEOA4; POLB; POLG-BETA; POLG2; POLGB
UniProt ID: (Human) Q9UHN1
Entrez Gene ID: (Human) 11232